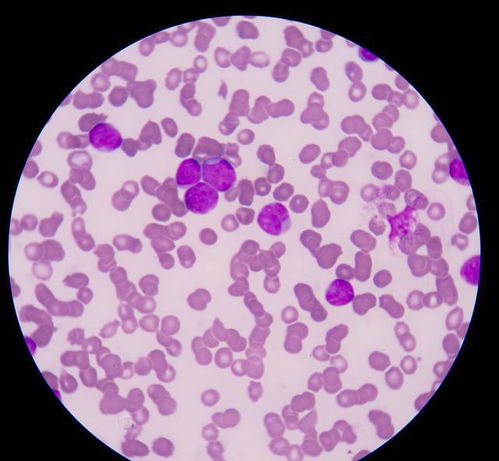
һ����ҩ�ΰ�֢���� ��֢������ҩ�����ɹ�����

一种中药治癌症晚期 癌症晚期中药治愈成功案例
癌症预防 2025-12-21 13:00癌症预防www.aizhengw.cn
中药在癌症晚期治疗中的角色与洞察
在生命的严峻挑战面前,癌症晚期的治疗尤为引人关注。中药的独特作用逐渐受到重视。它在癌症晚期治疗中,更多扮演的是辅助角色,但它的影响力不容小觑。这主要体现在缓解症状、减轻放化疗带来的副作用,以及提高患者的生活质量等方面。
对于特定的癌症类型,如肺癌、肝癌、乳腺癌等,中药似乎显现出了更突出的辅助治疗效果。这种效果可能来源于其独特的药理机制,如调节免疫功能、抑制肿瘤细胞生长等。在多种因素的共同作用下,中药在癌症治疗中发挥了积极的作用。
我们不能忽视一些振奋人心的治疗案例。比如那位74岁的肺癌晚期患者,通过纯中药治疗,肿瘤竟然完全消失,这一案例被载入国家成果库。但这样的案例是罕见的,并且与患者的体质及无法接受其他治疗方式有关。还有患者分享了自己通过中药结合其他自我康复方法延长生存期的经历,这无疑给人们带来希望,但每个人的情况都是独特的,不能一概而论。
在治疗过程中,我们必须明确一点:癌症治疗应遵循个体化原则。中药治疗需在专业中医师的精准指导下进行,根据患者的具体情况进行辨证施治。一些中药方剂虽然有所报道,但使用时必须谨慎,严格遵循医嘱。
我们也要认识到中药的局限性。对于病情严重、肿瘤较大的晚期癌症患者,单纯依赖中药可能无法有效控制病情。临床医生提醒我们,中药治疗癌症晚期主要是为了改善生活质量,而非根治。
建议癌症患者在选择治疗方案时,应全面考虑病情、身体状况以及专业医生的建议。中西医结合或许是一个更为稳妥的选择。对于具体的中药方剂,务必在正规医疗机构和经验丰富的医师指导下使用。让我们在尊重生命、尊重科学的共同为健康努力。
上一篇:癌症晚期会转为癌症吗
下一篇:没有了